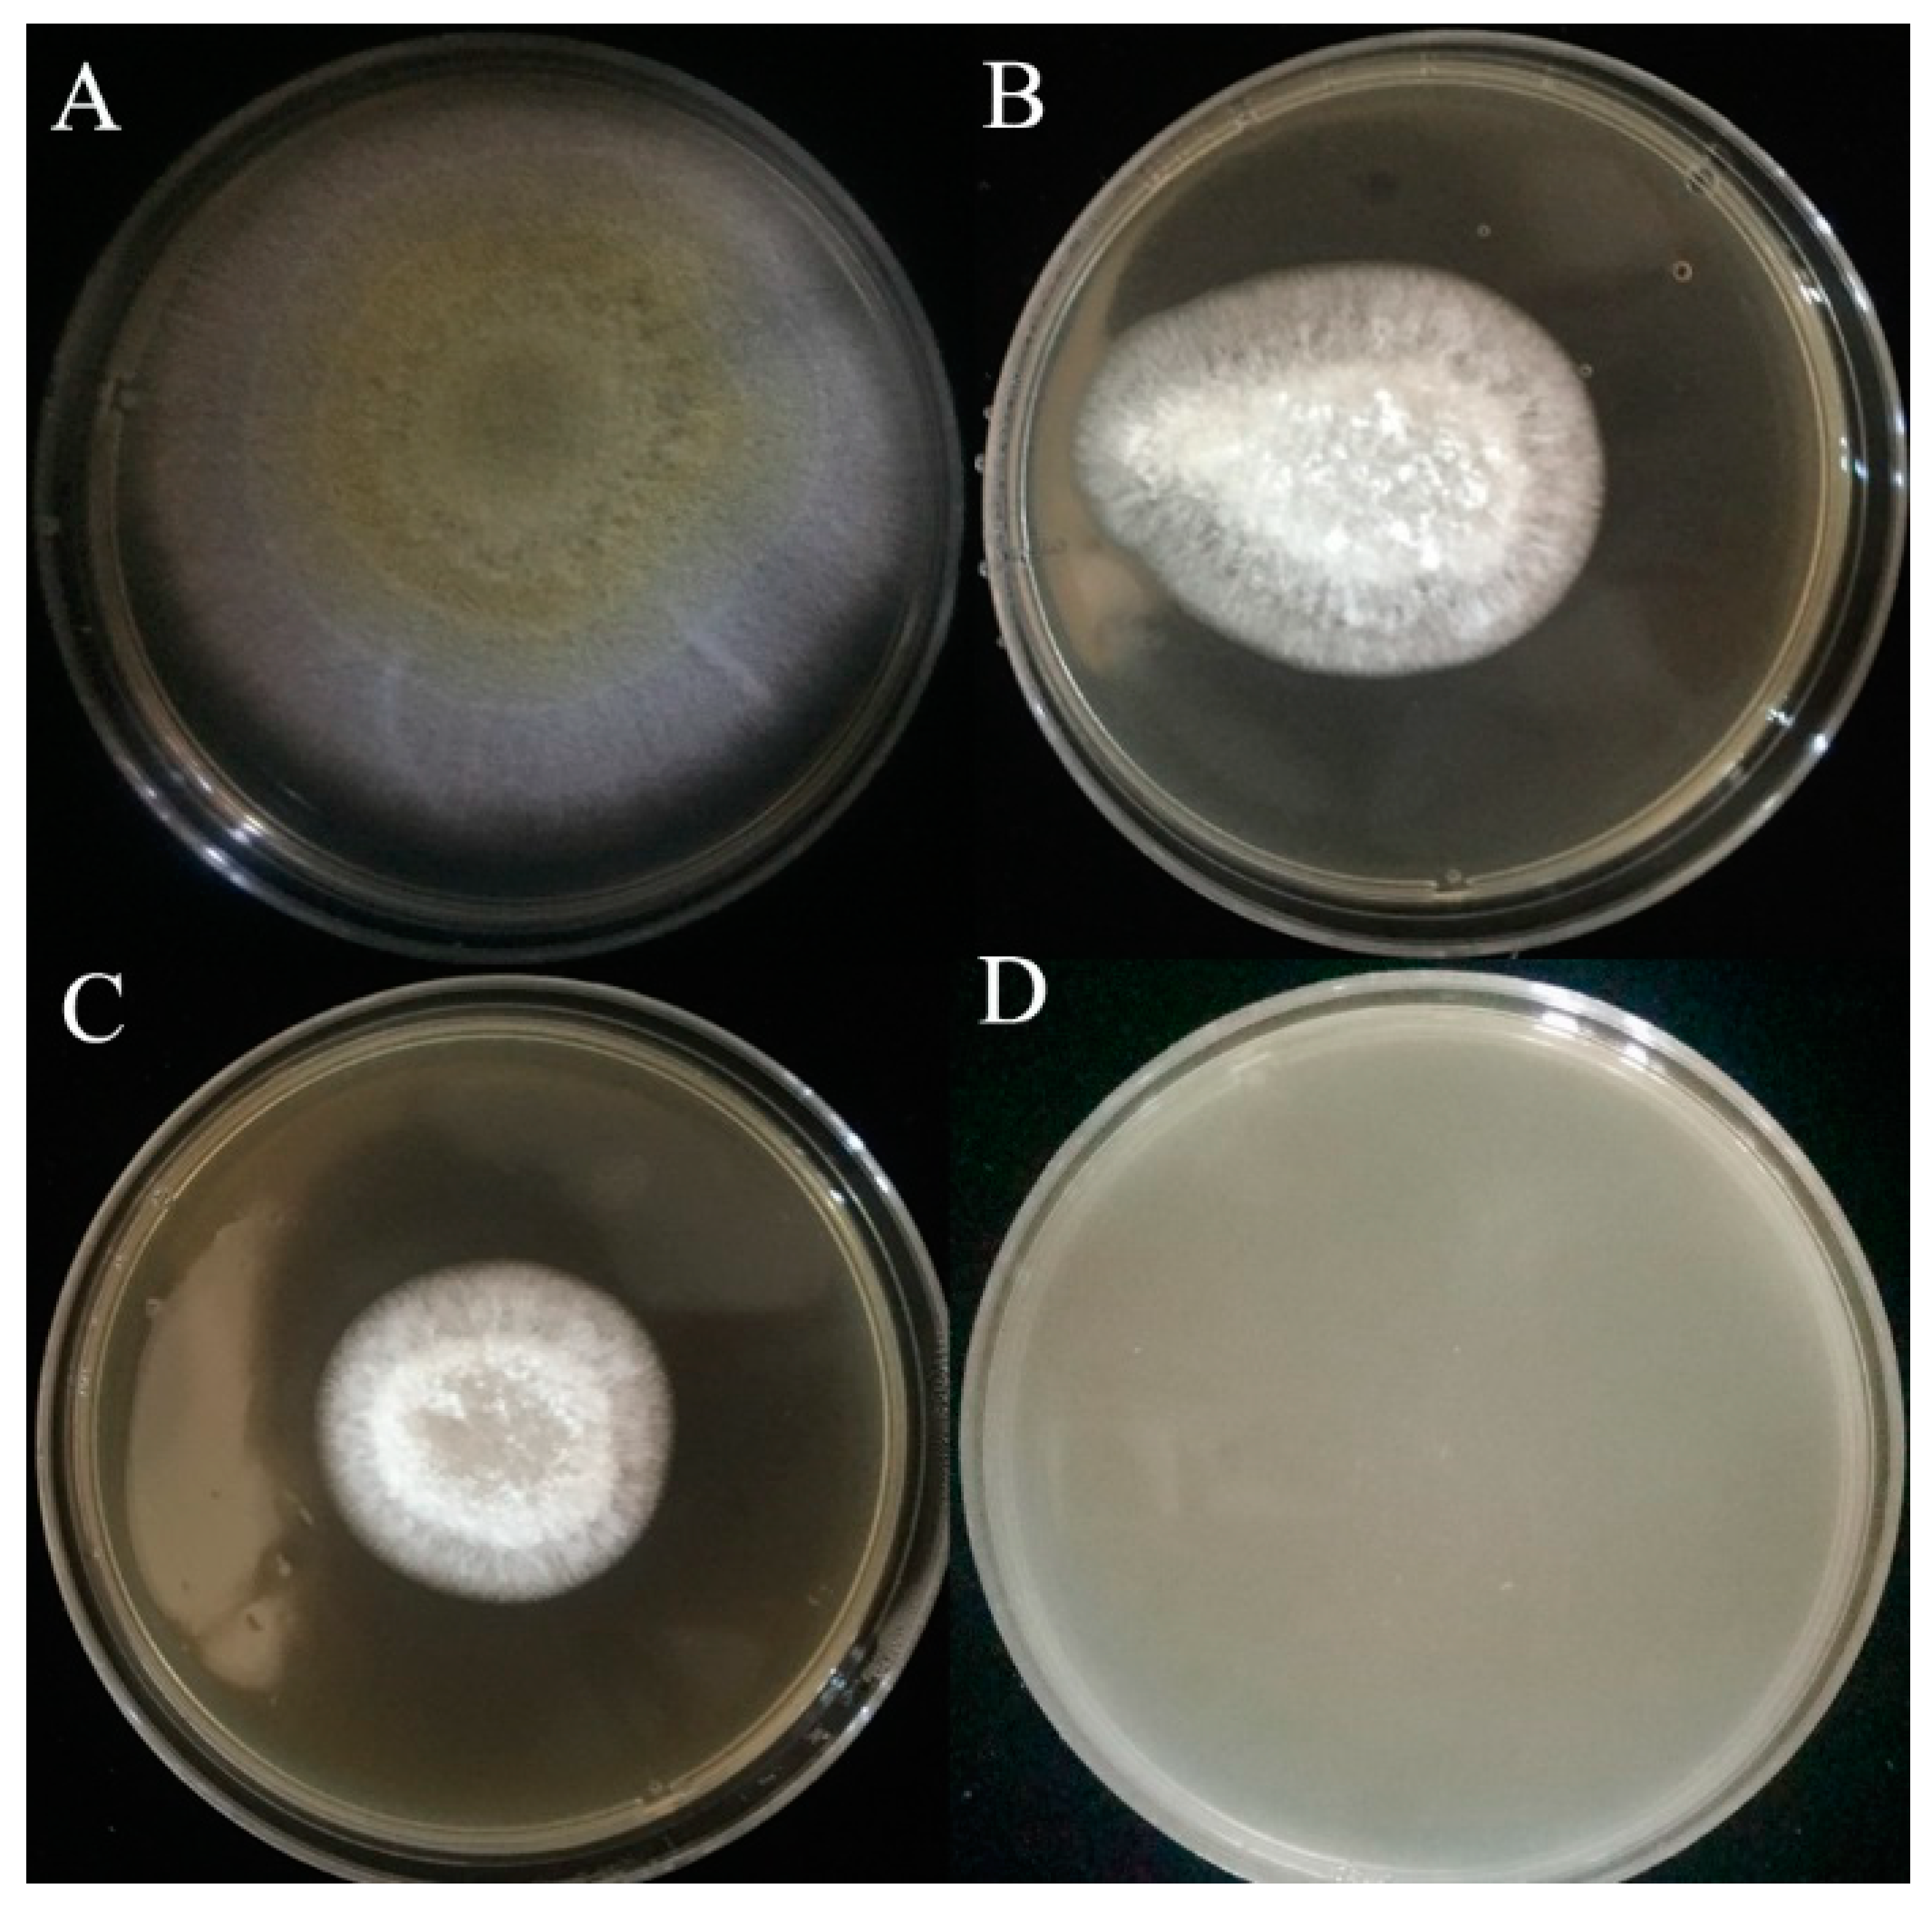
Toxins 11 00636 g002 Toxins 11 00636 g002
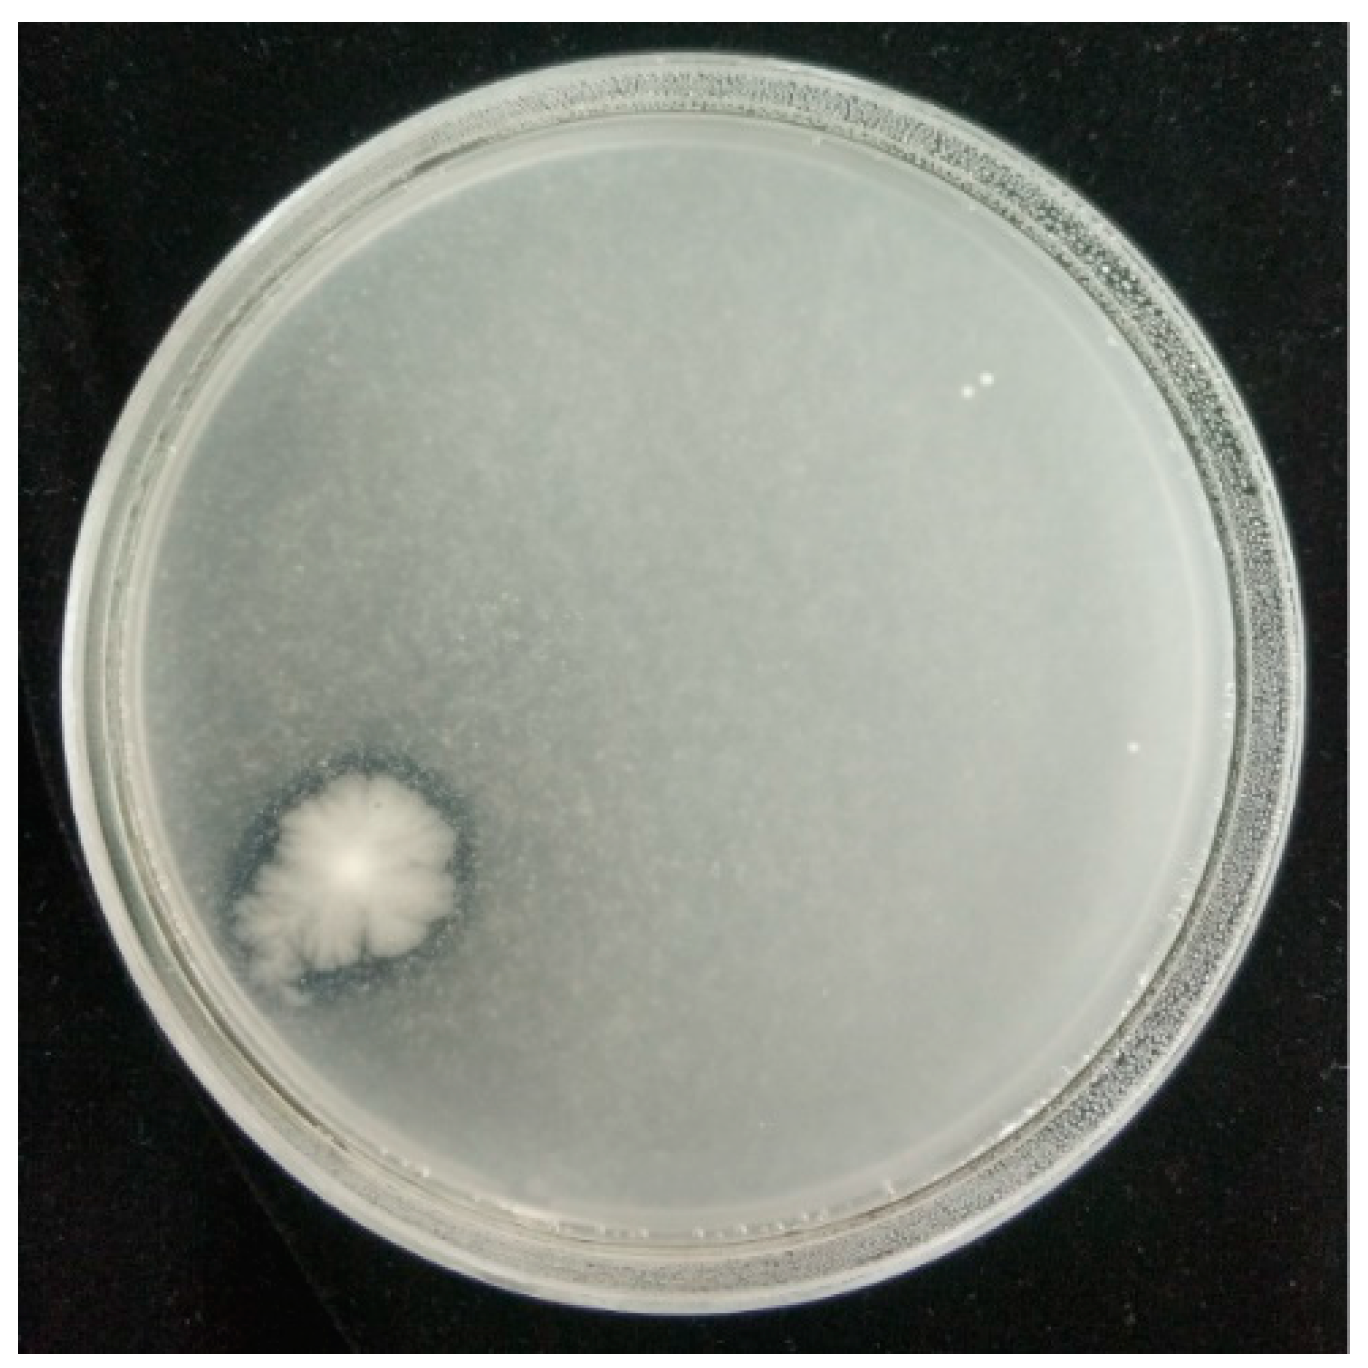
Toxins 11 00636 g005 Toxins 11 00636 g005

Morphological and Transcriptomic Analysis of the Inhibitory Effects of Lactobacillus plantarum on Aspergillus flavus Growth and Aflatoxin Production
Abstract
1. Introduction
2. Results
2.1. Screening of L. plantarum against A. flavus
2.2. Inhibitory Effect of L. plantarum IAMU80070 on A. flavus Growth
2.3. Inhibitory Effect of L. plantarum IAMU80070 on Aflatoxin Production
2.4. Effects of L. plantarum IAMU80070 on the Degradation and/or Sequestration of Aflatoxins
2.5. Effects of L. plantarum IAMU80070 on the Ultrastructure of A. flavus.
2.6. Chitinase Activity of L. plantarum IAMU80070
2.7. Comparison of Gene Expression among RNA-seq Groups
2.8. Functional Analysis and Classification of DEGs
2.9. Analysis of DEGs Associated with Aflatoxin Synthesis
2.10. qRT-PCR Validation of RNA-seq Data
2.11. Antifungal Activity in Bread
2.12. Antifungal Activity in Peanut Meal
3. Discussion
4. Materials and Methods
4.1. Chemicals, Media, Lactobacillus Plantarum and Aspergillus Strain
4.2. Primary Screening of L. plantarum Strains Inhibiting A. flavus Activity
4.3. Effects of L. plantarum Strain IAMU80070 on A. flavus Growth
4.4. Effects of L. plantarum Strain IAMU80070 on Aflatoxin B1 Production by A. flavus
4.5. Reduction of Aflatoxins Assay
4.6. Effects of Lactobacillus on the Ultrastructure of Aspergillus flavus
4.7. Production of Cell Wall Degrading Enzyme
4.8. RNA Sequencing, Annotation and Analysis
4.9. Quantitative Real-Time RT-PCR (qRT-PCR) Analysis
4.10. Antifungal Activity in Bread
4.11. Antifungal Activity in Peanut Meal
Supplementary Materials
Author Contributions
Funding
Acknowledgments
Conflicts of Interest
References
- Aflatoxins and Other Mycotoxins: An Agricultural Perspective. Available online: http://agris.fao.org/agris-search/search.do?recordID=US19820738458 (accessed on 1 November 2019).
- Diener, U.L.; Cole, R.J.; Sanders, T.H.; Payne, G.A.; Lee, L.S.; Klich, M.A. Epidemiology of Aflatoxin Formation by Aspergillus flavus. Annu. Rev. Phytopathol. 1987, 25, 249–270. [Google Scholar] [CrossRef]
- Guengerich, F.P.; Johnson, W.W.; Ueng, Y.-F.; Yamazaki, H.; Shimada, T. Involvement of cytochrome P450, glutathione S-transferase, and epoxide hydrolase in the metabolism of aflatoxin B1 and relevance to risk of human liver cancer. Environ. Health Perspect. 1996, 104, 557. [Google Scholar] [CrossRef] [PubMed]
- Hussein, H.S.; Brasel, J.M. Toxicity, metabolism, and impact of mycotoxins on humans and animals. Toxicology 2001, 167, 101–134. [Google Scholar] [CrossRef]
- Oliveira, P.M.; Zannini, E.; Arendt, E.K. Cereal fungal infection, mycotoxins, and lactic acid bacteria mediated bioprotection: From crop farming to cereal products. Food Microbiol. 2014, 37, 78–95. [Google Scholar] [CrossRef] [PubMed]
- Pawlowska, A.M.; Zannini, E.; Coffey, A.; Arendt, E.K. “Green preservatives”: Combating fungi in the food and feed industry by applying antifungal lactic acid bacteria. Adv. Food Nutr. Res. 2012, 66, 217–238. [Google Scholar] [CrossRef] [PubMed]
- Russo, P.; Arena, M.P.; Fiocco, D.; Capozzi, V.; Drider, D.; Spano, G. Lactobacillus plantarum with broad antifungal activity: A promising approach to increase safety and shelf-life of cereal-based products. Int. J. Food Microbiol. 2017, 247, 48–54. [Google Scholar] [CrossRef] [PubMed]
- Kachouri, F.; Ksontini, H.; Hamdi, M. Removal of aflatoxin B1 and inhibition of Aspergillus flavus growth by the use of Lactobacillus plantarum on olives. J. Food Prot. 2014, 77, 1760–1767. [Google Scholar] [CrossRef]
- Olonisakin, O.O.; Jeff-Agboola, Y.A.; Ogidi, C.O.; Akinyele, B.J. Isolation of Antifungal Lactic Acid Bacteria (LAB) from “Kunu” against Toxigenic Aspergillus flavus. Prev. Nutr. Food Sci. 2017, 22, 138–143. [Google Scholar] [CrossRef]
- Ahlberg, S.; Joutsjoki, V.; Laurikkala, S.; Varmanen, P.; Korhonen, H. Aspergillus flavus growth inhibition by Lactobacillus strains isolated from traditional fermented Kenyan milk and maize products. Arch. Microbiol. 2017, 199, 457–464. [Google Scholar] [CrossRef]
- Zielinska, K.J.; Fabiszewska, A.U. Improvement of the quality of maize grain silage by a synergistic action of selected Lactobacilli strains. World J. Microbiol. Biotechnol. 2017, 34, 9. [Google Scholar] [CrossRef]
- Cortes-Zavaleta, O.; Lopez-Malo, A.; Hernandez-Mendoza, A.; Garcia, H.S. Antifungal activity of Lactobacilli and its relationship with 3-phenyllactic acid production. Int. J. Food Microbiol. 2014, 173, 30–35. [Google Scholar] [CrossRef] [PubMed]
- Lavermicocca, P.; Valerio, F.; Visconti, A. Antifungal activity of phenyllactic acid against molds isolated from bakery products. Appl. Environ. Microbiol. 2003, 69, 634–640. [Google Scholar] [CrossRef] [PubMed]
- Lavermicocca, P.; Valerio, F.; Evidente, A.; Lazzaroni, S.; Corsetti, A.; Gobbetti, M. Purification and characterization of novel antifungal compounds from the sourdough Lactobacillus plantarum strain 21B. Appl. Environ. Microbiol. 2000, 66, 4084–4090. [Google Scholar] [CrossRef] [PubMed]
- Guimaraes, A.; Santiago, A.; Teixeira, J.A.; Venancio, A.; Abrunhosa, L. Anti-aflatoxigenic effect of organic acids produced by Lactobacillus plantarum. Int. J. Food Microbiol. 2018, 264, 31–38. [Google Scholar] [CrossRef] [PubMed]
- Poornachandra Rao, K.; Deepthi, B.V.; Rakesh, S.; Ganesh, T.; Achar, P.; Sreenivasa, M.Y. Antiaflatoxigenic Potential of Cell-Free Supernatant from Lactobacillus plantarum MYS44 Against Aspergillus parasiticus. Probiotics Antimicrob. Proteins 2017, 11, 55–64. [Google Scholar] [CrossRef]
- Yang, E.J.; Kim, Y.S.; Chang, H.C. Purification and characterization of antifungal delta-dodecalactone from Lactobacillus plantarum AF1 isolated from kimchi. J. Food Prot. 2011, 74, 651–657. [Google Scholar] [CrossRef]
- Dal Bello, F.; Clarke, C.I.; Ryan, L.A.M.; Ulmer, H.; Schober, T.J.; Strom, K.; Sjogren, J.; van Sinderen, D.; Schnurer, J.; Arendt, E.K. Improvement of the quality and shelf life of wheat bread by fermentation with the antifungal strain Lactobacillus plantarum FST 1.7. J. Cereal Sci. 2007, 45, 309–318. [Google Scholar] [CrossRef]
- Strom, K.; Sjogren, J.; Broberg, A.; Schnurer, J. Lactobacillus plantarum MiLAB 393 produces the antifungal cyclic dipeptides cyclo(L-Phe-L-Pro) and cyclo(L-Phe-trans-4-OH-L-Pro) and 3-phenyllactic acid. Appl. Environ. Microbiol. 2002, 68, 4322–4327. [Google Scholar] [CrossRef]
- Brul, S.; Coote, P. Preservative agents in foods. Mode of action and microbial resistance mechanisms. Int. J. Food Microbiol. 1999, 50, 1–17. [Google Scholar] [CrossRef]
- Jebali, R.; Abbes, S.; Salah-Abbes, J.B.; Younes, R.B.; Haous, Z.; Oueslati, R. Ability of Lactobacillus plantarum MON03 to mitigate aflatoxins (B1 and M1) immunotoxicities in mice. J. Immunotoxicol. 2015, 12, 290–299. [Google Scholar] [CrossRef]
- Zeng, Y.; Zeng, D.; Zhang, Y.; Ni, X.Q.; Wang, J.; Jian, P.; Zhou, Y.; Li, Y.; Yin, Z.Q.; Pan, K.C.; et al. Lactobacillus plantarum BS22 promotes gut microbial homeostasis in broiler chickens exposed to aflatoxin B1. J Anim. Physiol. Anim. Nutr. 2018, 102, e449–e459. [Google Scholar] [CrossRef] [PubMed]
- Moretti, A.F.; Gamba, R.R.; Puppo, J.; Malo, N.; Gomez-Zavaglia, A.; Pelaez, A.L.; Golowczyc, M.A. Incorporation of Lactobacillus plantarum and zeolites in poultry feed can reduce aflatoxin B1 levels. J. Food Sci. Technol. 2018, 55, 431–436. [Google Scholar] [CrossRef] [PubMed]
- Zhao, Y.; Selvaraj, J.N.; Xing, F.; Zhou, L.; Wang, Y.; Song, H.; Tan, X.; Sun, L.; Sangare, L.; Folly, Y.M.; et al. Antagonistic action of Bacillus subtilis strain SG6 on Fusarium graminearum. PLoS ONE 2014, 9, e92486. [Google Scholar] [CrossRef] [PubMed]
- Gow, N.A.; Latge, J.P.; Munro, C.A. The Fungal Cell Wall: Structure, Biosynthesis, and Function. In The Fungal Kingdom; ASM Press: Washington, DC, USA, 2017; pp. 267–292. [Google Scholar]
- Gourama, H.; Bullerman, L.B. Anti-aflatoxigenic activity of Lactobacillus casei pseudoplantarum. Int. J. Food Microbiol. 1997, 34, 131–143. [Google Scholar] [CrossRef]
- Karunaratne, A.; Wezenberg, E.; Bullerman, L.B. Inhibition of mold growth and aflatoxin production by Lactobacillus spp. J. Food Prot. 1990, 53, 230–236. [Google Scholar] [CrossRef]
- Coallier-Ascah, J.; Idziak, E.S. Interaction between Streptococcus lactis and Aspergillus flavus on production of aflatoxin. Appl. Environ. Microbiol. 1985, 49, 163–167. [Google Scholar] [CrossRef]
- Buchanan, R.L., Jr.; Ayres, J.C. Effect of initial pH on aflatoxin production. Appl. Microbiol. 1975, 30, 1050–1051. [Google Scholar]
- Cotty, P.J. Aflatoxin and Sclerotial Production by Aspergillus flavus: Influence of pH. Phytopathology 1988, 78, 1250–1253. [Google Scholar] [CrossRef]
- Luchese, R.H.; Harrigan, W.F. Growth of, and aflatoxin production by Aspergillus parasiticus when in the presence of either Lactococcus lactis or lactic acid and at different initial pH values. J. Appl. Bacteriol. 1990, 69, 512–519. [Google Scholar] [CrossRef]
- Kandler, O. Carbohydrate metabolism in lactic acid bacteria. Antonie Van Leeuwenhoek 1983, 49, 209–224. [Google Scholar] [CrossRef]
- Magnusson, J.; Strom, K.; Roos, S.; Sjogren, J.; Schnurer, J. Broad and complex antifungal activity among environmental isolates of lactic acid bacteria. FEMS Microbiol. Lett. 2003, 219, 129–135. [Google Scholar] [CrossRef]
- Gerbaldo, G.A.; Barberis, C.; Pascual, L.; Dalcero, A.; Barberis, L. Antifungal activity of two Lactobacillus strains with potential probiotic properties. FEMS Microbiol. Lett. 2012, 332, 27–33. [Google Scholar] [CrossRef] [PubMed]
- Sangare, L.; Zhao, Y.; Folly, Y.M.; Chang, J.; Li, J.; Selvaraj, J.N.; Xing, F.; Zhou, L.; Wang, Y.; Liu, Y. Aflatoxin B1 degradation by a Pseudomonas strain. Toxins 2014, 6, 3028–3040. [Google Scholar] [CrossRef] [PubMed]
- Tosch, D.; Waltking, A.E.; Schlesier, J.F. Comparison of liquid chromatography and high performance thin layer chromatography for determination of aflatoxin in peanut products. J. Assoc. Off. Anal. Chem. 1984, 2, 337–339. [Google Scholar]
- Marten, P.; Smalla, K.; Berg, G. Genotypic and phenotypic differentiation of an antifungal biocontrol strain belonging to Bacillus subtilis. J. Appl. Microbiol. 2010, 3, 463–471. [Google Scholar]
- Kim, D.; Langmead, B.; Salzberg, S.L. HISAT: A fast spliced aligner with low memory requirements. Nat. Methods 2015, 12, 357. [Google Scholar] [CrossRef]
- Li, H. The sequence alignment/map (sam) format. Bioinformatics 2009, 25, 1653–1654. [Google Scholar] [CrossRef]
- Wang, H.; Lei, Y.; Yan, L.; Cheng, K.; Dai, X.; Wan, L.; Guo, W.; Cheng, L.; Liao, B. Deep sequencing analysis of transcriptomes in Aspergillus flavus in response to resveratrol. BMC Microbiol. 2015, 15, 182. [Google Scholar] [CrossRef]
- Wang, B.; Han, X.; Bai, Y.; Lin, Z.; Qiu, M.; Nie, X.; Wang, S.; Zhang, F.; Zhuang, Z.; Yuan, J.; et al. Effects of nitrogen metabolism on growth and aflatoxin biosynthesis in Aspergillus flavus. J. Hazard. Mater. 2017, 324, 691–700. [Google Scholar] [CrossRef]
- Livak, K.; Schmittgen, T. Analysis of Relative Gene Expression Data Using Real-Time Quantitative PCR and the 2−△△Ct Method. Methods 2000, 25, 4. [Google Scholar]
- Coda, R.; Rizzello, C.G.; Nigro, F.; De Angelis, M.; Arnault, P.; Gobbetti, M. Long-term fungal inhibitory activity of water-soluble extracts of phaseolus vulgaris cv. pinto and sourdough lactic acid bacteria during bread storage. Appl. Environ. Microbiol. 2008, 74, 7391–7398. [Google Scholar] [PubMed]
- Ström, K. Fungal Inhibition Lactic Acid Bacteria: Characterization and Application of Lactobachillus Plantarum MiLAB 393. Ph.D. Thesis, Swedish University of Agricultural Sciences, Uppsala, Sweden, 2005; pp. 1–39. [Google Scholar]

| Strain No. | Strain No. | Origin | Growth Inhibition a |
|---|---|---|---|
| 1 | IMAU20063 | Acid camel milk from Mongolian state | ++ |
| 2 | IMAU10570 | Acid horse milk from Inner Mongolia Hulun Buir League | ++ |
| 3 | IMAU10704 | Acid horse milk from Inner Mongolia Hulun Buir League | + |
| 4 | IMAU70164 | Acid porridge from Hohhot City | + |
| 5 | IMAU40089 | Acid yak milk from Qinghai Haibeizhou | + |
| 6 | IAMU80070 | Kimchi from Huaiyuan Town, Chongzhou City, Sichuan Province | +++ |
| 7 | IMAU80178 | Kimchi from Pujiang County, Sichuan Province | + |
| 8 | IMAU60049 | Yogurt from Suncheon, Tibet | ++ |
| 9 | IMAU80597 | Qura from Xiahe County, Gansu Province | + |
| 10 | IMAU10725 | Yogurt from Inner Mongolia Arukol Banner | + |
| 11 | IMAU10969 | Yogurt from Inner Mongolia Bahrain Youqi Daban Town | + |
| 12 | IMAU10145 | Goat milk from Bayannaoer City, Inner Mongolia | + |
| 13 | IMAU10124 | Fermented cream from Bayannaoer City, Inner Mongolia | + |
| 14 | IMAU10278 | Sour dough from Baotou City, Inner Mongolia | + |
| 15 | IMAU10386 | Yogurt Inner Mongolia Hulunbeier League | + |
| 16 | IMAU10586 | Sour horse milk from Hulunbeier League, Inner Mongolia | + |
| 17 | IMAU40001 | Sour horse milk from Haixi, Qinghai | + |
| 18 | IMAU40091 | Sour milk from Haibei, Qinghai | + |
| 19 | IMAU40100 | Sour milk from Haibei, Qinghai | + |
| 20 | IMAU80441 | Fresh milk from Aba, Sichuan | + |
| 21 | IMAU60026 | Sour milk from Shigatse Prefecture, Tibet | + |
| 22 | IMAU30001 | Sour horse milk from Xinjiang Yili Prefecture | + |
| No. | Strain No. | AFB1 Reduction | AFB2 Reduction | AFG1 Reduction | AFG2 Reduction |
|---|---|---|---|---|---|
| 1 | IAMU80070 | 7.9% ± 2.9% | 5.2% ± 0.5% | 2.3% ± 1.5% | 6.4% ± 0.1% |
| Sample | Total Reads | Mapped Reads | Mapping Rate (%) |
|---|---|---|---|
| CK1 | 43,060,056 | 37,785,199 | 87.75 |
| CK2 | 39,269,612 | 34,231,320 | 87.17 |
| CK3 | 41,770,838 | 35,939,629 | 86.04 |
| T4 | 39,589,518 | 33,710,475 | 85.15 |
| T5 | 38,192,168 | 32,505,354 | 85.11 |
| T7 | 40,226,730 | 34,502,466 | 85.77 |
| Term | ID | Gene Number | Rich Factor | p-Value | Corrected p-Value | Note |
|---|---|---|---|---|---|---|
| Aflatoxin biosynthesis | afv00254 | 7 | 0.50 | 2.3 × 10−10 | 6.5 × 10−9 | Down regulated |
| Pentose phosphate pathway | afv00030 | 3 | 0.10 | 2.7 × 10−3 | 3.9 × 10−2 | Down regulated |
| Pyruvate metabolism | afv00620 | 3 | 0.08 | 5.3 × 10−3 | 4.0 × 10−2 | Down regulated |
| Carbon metabolism | afv01200 | 5 | 0.04 | 5.5 × 10−3 | 4.0 × 10−2 | Down regulated |
© 2019 by the authors. Licensee MDPI, Basel, Switzerland. This article is an open access article distributed under the terms and conditions of the Creative Commons Attribution (CC BY) license (http://creativecommons.org/licenses/by/4.0/).
Share and Cite
Zhao, Y.; Zhang, C.; Folly, Y.M.E.; Chang, J.; Wang, Y.; Zhou, L.; Zhang, H.; Liu, Y. Morphological and Transcriptomic Analysis of the Inhibitory Effects of Lactobacillus plantarum on Aspergillus flavus Growth and Aflatoxin Production. Toxins 2019, 11, 636. https://doi.org/10.3390/toxins11110636
Zhao Y, Zhang C, Folly YME, Chang J, Wang Y, Zhou L, Zhang H, Liu Y. Morphological and Transcriptomic Analysis of the Inhibitory Effects of Lactobacillus plantarum on Aspergillus flavus Growth and Aflatoxin Production. Toxins. 2019; 11(11):636. https://doi.org/10.3390/toxins11110636
Chicago/Turabian StyleZhao, Yueju, Chenxi Zhang, Yawa Minnie Elodie Folly, Jinghua Chang, Yan Wang, Lu Zhou, Heping Zhang, and Yang Liu. 2019. "Morphological and Transcriptomic Analysis of the Inhibitory Effects of Lactobacillus plantarum on Aspergillus flavus Growth and Aflatoxin Production" Toxins 11, no. 11: 636. https://doi.org/10.3390/toxins11110636
APA StyleZhao, Y., Zhang, C., Folly, Y. M. E., Chang, J., Wang, Y., Zhou, L., Zhang, H., & Liu, Y. (2019). Morphological and Transcriptomic Analysis of the Inhibitory Effects of Lactobacillus plantarum on Aspergillus flavus Growth and Aflatoxin Production. Toxins, 11(11), 636. https://doi.org/10.3390/toxins11110636
